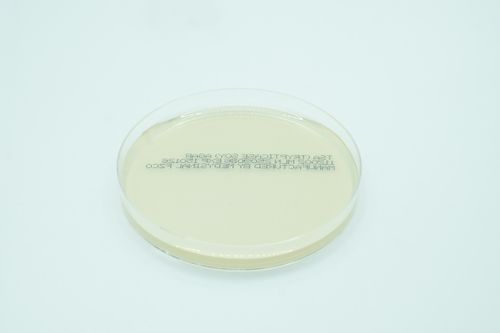

%201.png)






%20(3).png)








%20Broth%2C%205%20ml%201.png)

%20(4).png)





Sheep Blood Agar / Mueller Hinton Agar biplate is highly nutritious general purpose medium for the isolation and cultivation of nonfastidious and fastidious microorganisms and used for antimicrobial susceptibility testing of rapidly growing aerobic micro organism by disc diffusion technique.
Pack Size: 10
Certifications: U.A.E MOH, CE, Free sale certificate, SFDA
